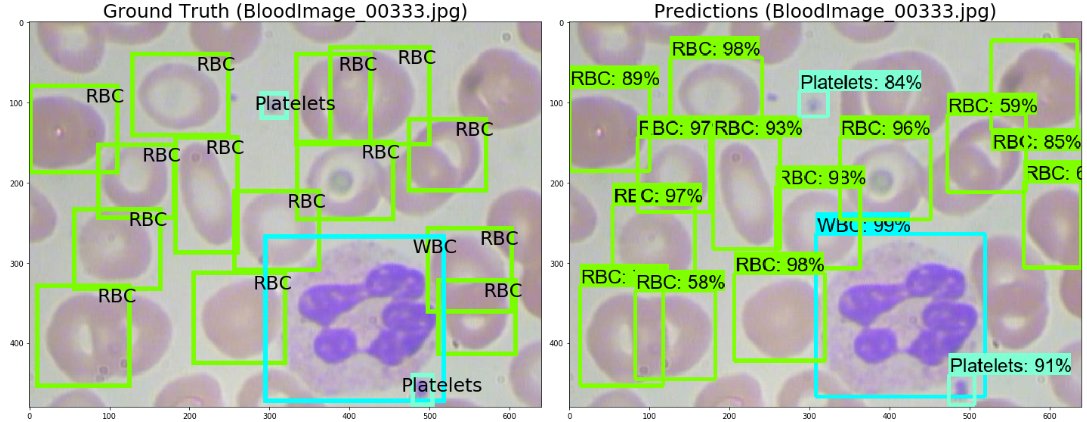

Deep cell
Топ эхолотов для лодки пвх
Formula ice 205 65 r16 99t xl
11 апреля 2011 года
Распределите по классам следующие соединения al2 so4
Калории в 100 гр яблока
Провоз оборудования аэрофлот
Теле шоу все
Как вводить микролакс взрослому видео
Дельта х роблокс на телефон
Пенсия с 1 апреля 25 года
Texet 218
Роль изобразительной деятельности в развитии ребенка
Подорожник отек
Deep cell 112 фотографий